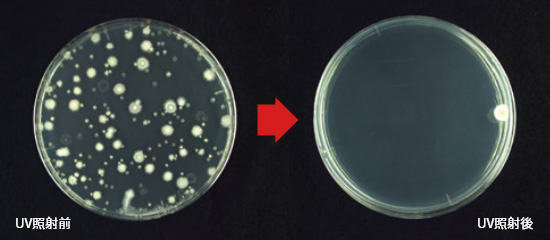

商品紹介 UVライティング UV技術で、未来へ−紫外線イノベーション 紫外線除菌の有効性
ウイルスや細菌がもつDNA/RNAに直接作用するので、アルコールなどが効かないウイルスにも効果があります。
※菌の種類(大きさ、形状他)や環境などにより、除菌に必要な照射量は大幅に異なり、効果が得られない場合もあります。

長時間使用した薬に対して、抵抗性を持ち、効きづらくなる耐性菌。紫外線ならその心配がありません。

紫外線照射して物体表面を除菌する場合、アルコールや次亜塩素酸水などの薬剤では必要な拭き取りが不要です。

水や食物に対して常温での除菌が可能。加熱・蒸気など高温による菌処理では気になる風味への影響を抑えます。



※浮遊ウイルス密度変化のシミュレーション(イメージ)
枯草菌に対するUV照射

東芝ライテックでは、紫外線UV-C光源による各種ウイルス、菌への有効性を第三者機関や社内での評価試験により確認しています。
新型コロナウイルス(SARS-CoV-2)に対しては、国立大学法人山口大学(共同獣医学部早坂大輔教授、下田宙准教授)でのウイルス力価を測定するシャーレ試験において、各種波長のUV-C光源によるウイルス抑制効果があることを確認しています。

| 試験対象 | 試験機関 | ||
|---|---|---|---|
| ウイルス | インフルエンザウイルス(H1N1) | シャーレ | 国立大学法人山口大学 |
| インフルエンザウイルス(H1N1) | 空気中 | 食環境衛生研究所 | |
| 鳥インフルエンザウイルス(H5N1) | シャーレ | 国立大学法人北海道大学 | |
| ネコカリシウイルス | シャーレ | 国立大学法人山口大学 | |
| バクテリオファージΦx174 | 空気中 | 日本食品分析センター | |
| 菌 | 黄色ブドウ球菌 | 空気中 | 北里環境科学センター |
| 黄色ブドウ球菌 | 培地 | 微生物衛生研究所 | |
| 大腸菌 | 培地 | 微生物衛生研究所 | |
| 大腸菌 | 水中 | 日本食品分析センター | |
| 枯草菌 | 水中 | 日本食品分析センター | |
| グラム陽性菌 | 培地 | 当社 | |
| カビ | カンキツ緑かび病菌 | 培地 | 当社 |
細菌(グラム陰性菌、グラム陽性菌)、真菌、ウイルス、原生動物など全71種の微生物について、不活化に必要な照射線量を紹介しております。
本表は、東京大学 小熊久美子教授の学術指導のもとに作成しております。また、一部情報についてはユーザー登録が必要になります。
※1 株名:特定の微生物の系統を示す名称、あるいは分譲機関の番号。
※2 宿主:生物が寄生・共生する場合の相手の生物、即ち、評価試験を実施した際のホスト。
※3 光源:評価試験を実施した際の紫外線光源、LPは低圧紫外線ランプ、MPは中圧紫外線ランプ。
※4 UV照射量:記載のアラビア数字は各微生物の常用対数減少率を示す。例えば、「1」の下には1桁減少(90%減少)させるために必要なUV照射量が記載されている。
※5 プロトコル:引用文献に実験方法の明記についての有無
参考文献:IUVA Fluence (UV Dose) Required to Achieve Incremental Log Inactivation of Bacteria, Protozoa, Viruses and Algae
作成年月:2025年1月